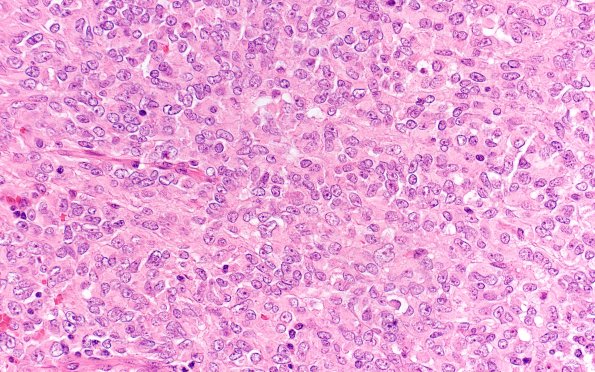
19C3 ATRT (Case 19) H&E 40X 2

Table of Contents
Washington University Experience | NEOPLASMS (EMBRYONAL) | ATRT - Atypical Teratoid Rhabdoid Tumor | 19C3 ATRT (Case 19) H&E 40X 2
Most of the tumor cells show rhabdoid morphology with abundant eosinophilic cytoplasm and round, eccentric, nuclei with vesicular chromatin and macronucleoli. Intracytoplasmic inclusions are apparent in a subset. Mitoses are numerous. (H&E)